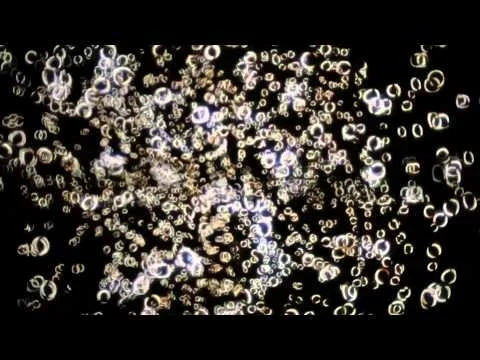

Divine Coalescence
June 14, 2012
Berlin
In concert with Glowing Bulbs Visual Arts Organization, and opera star Nadja Michael, Curator Leo Kuelbs presents “Divine Coalescence,” a one-time video mapped projection at the Bärensaal in the Alte Stadthaus, Berlin. As the centerpiece of Dom Perignon’s “Creators Event,” “Divine Coalescence” explores the quest for balance through understanding and immersion in complex systems that span history, mythology, science, culture and art. “Divine Coalescence” marks the point where the artist (or other creator of an intentional object) chooses to ultimately orchestrate a combination of the ingredients necessary to achieve a perfect, desired balance. A sense of constructive collaboration is necessary in the creation of each vintage of Dom Perignon, as it is in the creation of “Divine Coalescence,” a truly singular event, to be presented only once to the public. The event itself is the essence of its conceptual creation.
Past Dom Perignon Creative Partners include:
Karl Lagerfeld, Marc Newson, Ferran Adrià, Sylvie Fleury, Lang Lang, Robert Wilson and David Lynch.
"Divine Coalescence" Press Links:
Interview.de
Vogue.de
Sleek Magazine
Tagesspiegel
Berlin Artlink
Eyes Toward the Dove (Pre-Event)
Eyes Toward the Dove (Post-Event)
Kunst Magazine
Pet Fanclub
Video by FirmaFormat